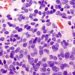
Proton radiotherapy for pediatric medulloblastoma demonstrates acceptable toxicity in phase 2 study

Metformin linked to reduced weight gain and improved insulin sensitivity in obese pregnant women without diabetes
1. In women who had a BMI of more than 35, antenatal administration of metformin significantly reduced maternal weight gain.
2. There was no significant difference in median neonatal birth-weight between the metformin and placebo groups.
Evidence Rating Level: 1 (Excellent)
Study Rundown: An estimated one-third of pregnant women in the United States are obese. Lifestyle-intervention studies have not shown improved pregnancy outcomes, and have been generally unsuccessful. Obesity is associated with hyperglycemia and insulin resistance, both of which promote complications such as fetal macrosomia and transient hypoglycemia. Metformin has been shown to increase insulin sensitivity and reduce gestational weight gain in women with gestational diabetes.
Women without diabetes who had a BMI of greater than 35 at 12 to 18 weeks of gestation were randomized to receive metformin or placebo on their first visit after randomization. All the women received advice on healthy eating and exercise. Metformin was initiated at a daily dose of 1.0 g in week 1, and the dose was increased by 0.5 g daily per week to a maximum daily dose of 3.0g. The primary outcome was neonatal birth-weight. None of the fetal/neonatal secondary outcomes demonstrated a significant between-group difference. Maternal weight gain was significantly less in the metformin group compared to placebo. Furthermore, the proportion of women that developed preeclampsia was significantly less in the metformin group compared to placebo. This study draws strength from its racially heterogeneous sample population and their high rate of adherence to the study regimen, but it is limited by underpowering in the secondary outcomes, due to an insufficient recruitment of patients in the study.
Click to read the study, published today in NEJM
Relevant Reading: Pregnancy outcomes in women with gestational diabetes treated with metformin or insulin: a case–control study
In-Depth [randomized controlled trial]: Fetal/neonatal outcomes that were not found to show a significant between-group difference were percentage of: miscarriage (p = 0.12), stillborn (p=0.62), neonatal death (p = 0.49), live birth (p = 0.12), delivered at <37 weeks gestation (p=0.12), median birth weight percentile (p = 0.66), large for gestational age (p=0.79), birth trauma (p=1.00), Apgar score <7 at 5 min (p=0.36), NICU admission (p=0.47), hypoglycemia (p=0.58), hyperbilirubinemia (p=0.36), respiratory distress syndrome (p=0.33). Two of the maternal outcomes demonstrated a significant difference: median maternal weight gain (metformin, 4.6kg vs. placebo 6.3kg; p<0.001) and proportion that developed preeclampsia (metformin, 3% vs. placebo 11.3%; p=0.001).
There was no significant difference between the metformin group and the placebo group in the median neonatal birth-weight z score (p=0.66). Maternal outcomes that were not found to show a significant between-group difference were percentage of: gestational diabetes mellitus (p=0.74), pregnancy-induced hypertension (p=0.93), delivery by caesarian section (p=0.79), and postpartum hemorrhage (p=0.67).
Image: PD
©2016 2 Minute Medicine, Inc. All rights reserved. No works may be reproduced without expressed written consent from 2 Minute Medicine, Inc. Inquire about licensing here. No article should be construed as medical advice and is not intended as such by the authors or by 2 Minute Medicine, Inc.